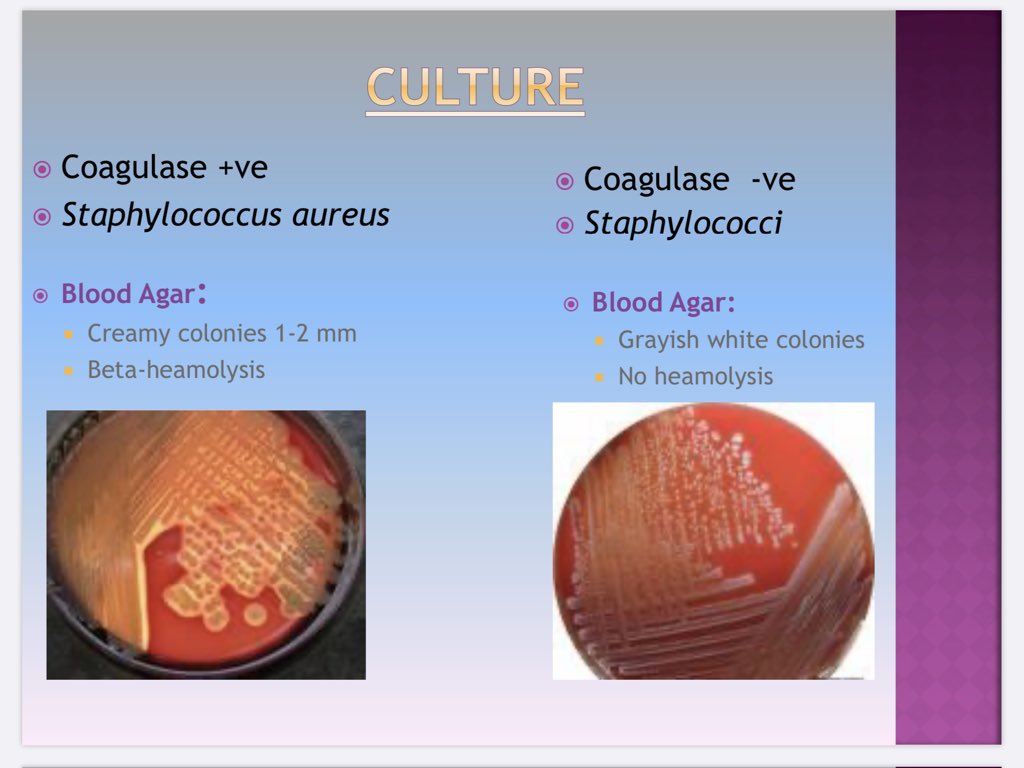
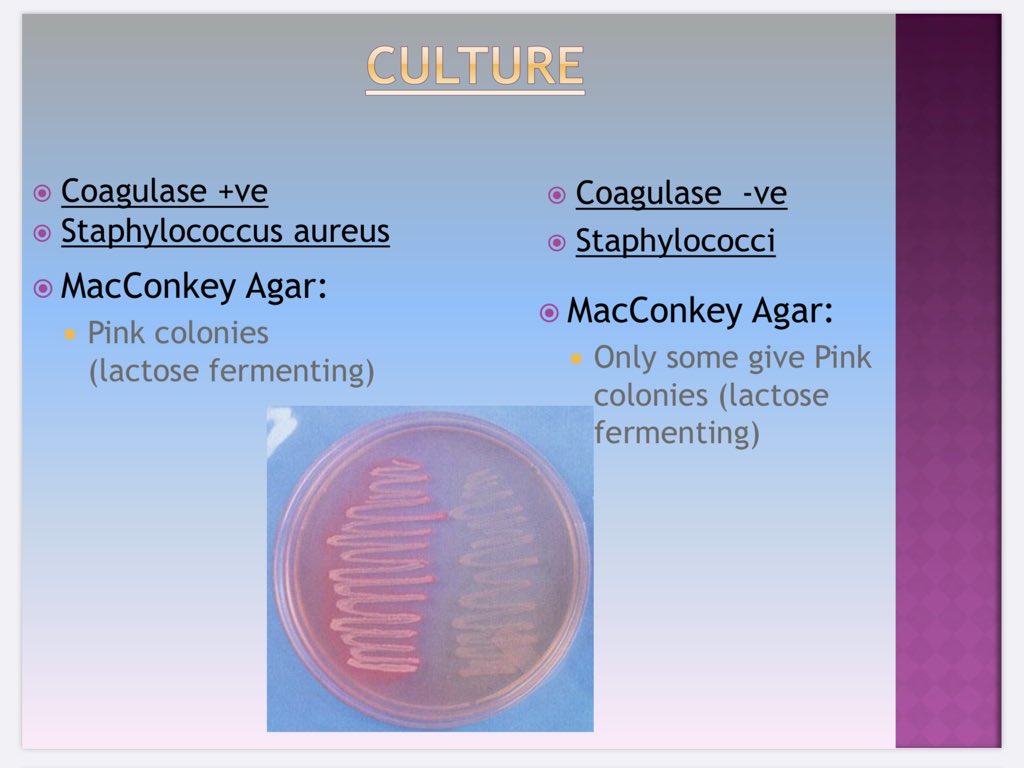
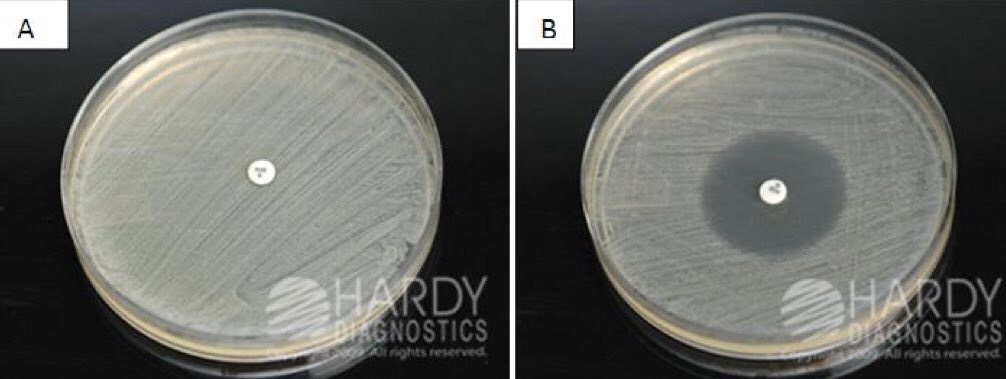

كُتب lippincott هو دائمًا صديق الطلبة لسهولة لغته وبساطته في الشرح، وهذا الكتاب يشرح فيه أساسيات الـ Microbiology لذلك ننصح به🤩
#cls437
#cls437
Why gram +ve organisms resist decolorization, while gram -ve get decolorized?
#cls437
#cls437
General characteristics of the Enterobactericeae :
✔️Rod shaped
✔️Gram negative
✔️Catalase positive
✔️Oxidase negative
✔️Facultative anaerobes
✔️Most ferment glucose, some are LF
✔️Most reduce nitrate to nitrite
#cls437 #Bacteriology
✔️Rod shaped
✔️Gram negative
✔️Catalase positive
✔️Oxidase negative
✔️Facultative anaerobes
✔️Most ferment glucose, some are LF
✔️Most reduce nitrate to nitrite
#cls437 #Bacteriology
In Xylose Lysine Desoxycholate Agar (XLD) All enterics ferment xylose except :
* ferment xylose gives yellow colonies
#cls437 #bacteriology
* ferment xylose gives yellow colonies
#cls437 #bacteriology
Antibiotics are natural or synthetic products that are used to kill or stop the growth of Bacteria:
✔️ Bacteriostatic: stop growth (don't kill)
✔️ Bactericidal: kill
#cls437 #Bacteriology
✔️ Bacteriostatic: stop growth (don't kill)
✔️ Bactericidal: kill
#cls437 #Bacteriology
- Why do we do sensitivity testing?
1. To know which drug we use to the patient.
2. To know the dose of antibiotics.
“It is important to use the lowest effective concentration of the antibiotic to avoid toxicity in patient”
#cls437 #Bacteriology
1. To know which drug we use to the patient.
2. To know the dose of antibiotics.
“It is important to use the lowest effective concentration of the antibiotic to avoid toxicity in patient”
#cls437 #Bacteriology
Broth dilution is a method used in antibiotic sensitivity test. Therefore, if all tubes are turbid it is due to:
#cls437 #Bacteriology
#cls437 #Bacteriology
Agar diffusion is another sensitivity test method, it could be:
- Kirby-Bauer: measure inhibition zone to assess if zone size indicates resistance or sensitivity.
- Stock’s method:comparison between zones seen with the test organism & those of the known sensitive control
#cls437
- Kirby-Bauer: measure inhibition zone to assess if zone size indicates resistance or sensitivity.
- Stock’s method:comparison between zones seen with the test organism & those of the known sensitive control
#cls437
Muller Hinton Medium: It is a special media used for sensitivity testing and it dose not interfere with test results.
#cls437 #Bacteriology
#cls437 #Bacteriology
Staphylococcus sp:
✔️ Gram positive cocci in clusters.
✔️ Facultative anaerobes.
✔️ Incubation 37°C x 24hr.
✔️ All Staphylococci are CATALASE +VE
#cls437 #baceriology
✔️ Gram positive cocci in clusters.
✔️ Facultative anaerobes.
✔️ Incubation 37°C x 24hr.
✔️ All Staphylococci are CATALASE +VE
#cls437 #baceriology
Biochemical tests are:
1. Catalse +ve
2. Coagulase +ve “Staphylococcus aureus”
3. DNase
#cls437 #baceriology
1. Catalse +ve
2. Coagulase +ve “Staphylococcus aureus”
3. DNase
#cls437 #baceriology
- Coagulase negative staphylococcus:
✔️ NOVOBIOCIN Disk:
Staphylococcus saprophyticus → Resistant
Staphylococcus epidermidis → Sensitive
#cls437 #Bacteriology
✔️ NOVOBIOCIN Disk:
Staphylococcus saprophyticus → Resistant
Staphylococcus epidermidis → Sensitive
#cls437 #Bacteriology
جاري تحميل الاقتراحات...